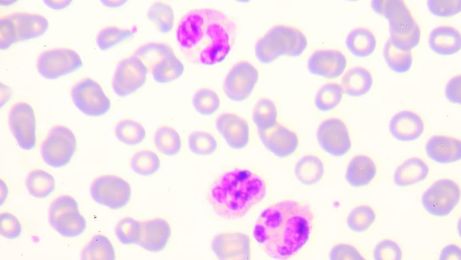
吃辣条引起的过敏性紫癜能恢复吗,吃辣得过敏性紫癜能自愈吗

最近中科血康史淑荣主任诊断很多过敏性紫癜的病人,最大的38岁,最小的5岁,以6-18的儿童和青少年居多。
诊断发现他们发病前均喜欢吃“辣条”、“辣片”、“辣串”之类的东西,都有吃这些食品的历史,轻者过敏性紫癜,严重者可引起消化道出血、过敏性紫癜肾炎。比较典型的病例是一30男性,平素身体健康,喜饮酒,去年买了一箱辣条,做下酒菜,半月后,出现过敏性紫癜,进而发展为过敏性紫癜肾炎。一旦发病后,要抓紧治疗,不要耽搁,中西医结合治疗,多数可痊愈。

过敏性紫癜肾炎是一种免疫性疾病,好发于儿童及青少年。发病者多为过敏性体质,食用牛奶、虾、鱼、蛋、羊肉、龙虾、海鲜等动物蛋白,以及不干净的豆制品等食物后引发。

史主任提醒家长,孩子正值发育期间,一定要注意饮食卫生,没有包装、没有生产日期的食品坚决不能食用,而且尽量少吃或不吃易过敏的食物。
过敏性紫癜的现实治疗中,有不少过敏性紫癜患者会出现久治不愈、反复发作的情况,患者甚至长期遭受过敏性紫癜的折磨。过敏性紫癜可以分为多种,无论哪种类型的过敏性紫癜严重时都可侵害到肾脏,患者千万不能忽视。

过敏性紫癜久治不愈会怎样?
很多人都想要知道这个问题,因为该病的发生经常会给患者带来很大的困扰。如果久治不愈,会不会引发其他一些疾病?过敏性紫癜患者能发展成为什么疾病呢?今天,史主任就为大家介绍一下过敏性紫癜久治不愈会怎么样?

其实,如果得了过敏性紫癜,大家不要害怕,这种疾病多为自限性,一般在6一8周内好转,而且预后良好,当然,也有一少部分病例可反复发作达数年之久。过敏性紫癜还可能会累及其它器官,产生一些疾病,如果有关节受累的患者,大家也不要太过着急,这种症状很少会遗留关节畸形。

一般下只要3个月内患儿情况平稳,以后复发的可能性就会很小,但是如果过敏性紫癜久治不愈,时间超过3个月,复发概率就会增多。在该病的并发症中,较严重的就是引起过敏性紫癜肾炎,发展为紫癜性肾炎的患儿只要正规治疗,大多可,只有少数病例发展为慢性肾炎、肾功能不全,肾衰竭死亡病例仅占紫癜性肾炎的0.1 。

看来以上对过敏性紫癜患者久治不愈会怎样的介绍。史主任建议患者:治疗过敏性紫癜,一定要有坚定的信心和顽强的毅力,保持豁达开朗的精神状态,才能充分调动自身的抗病潜能,较终战胜疾病获得 。